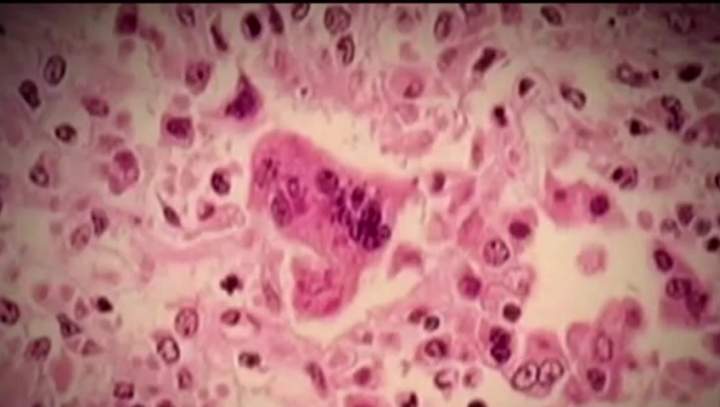

Peel Public Health
-
Case of measles found in Ontario child with recent travel historyPeel Public Health said it has confirmed a case of measles in a child with a recent history of international travel.HealthFeb 14, 2024
-
Peel Region reports 1st case of monkeypox virus in MississaugaOn Monday, the health unit said the case was detected in a man in his 30s living in Mississauga.HealthJun 27, 2022

-
-
Advertisement
-
Lawrence Loh, Peel’s top doctor, set to depart front-line pandemic roleDr. Lawrene Loh took on Peel's top health-care job in the early months of the pandemic, after his predecessor, Dr. Jessica Hopkins, accepted a role with Public Health Ontario.HealthMay 25, 2022
![]()
-
-
Advertisement
-
Patrons who attended Mississauga wedding asked to get tested for COVID-19Peel Public Health said the wedding event was held at Apollo Convention Centre at 6591 Innovator Dr. in Mississauga on Oct. 29.HealthNov 9, 2021
![]()
-
Guests of 2 wedding events in Mississauga urged to seek ‘immediate’ COVID-19 testingHealth officials said all individuals who went to either event should get tested regardless of their vaccination status.HealthOct 18, 2021
![]()
-
-
Attendees of wedding events at Mississauga hall urged to get tested due to COVID-19 exposureThose who are not fully vaccinated are required to self-isolate until the end of day on Oct. 6, officials said.HealthOct 1, 2021
![]()
-
-
Attendees of GTA wedding urged to seek testing, self-isolate due to COVID-19 exposurePeel Public Health said the advisory applies to all guests, including those who are fully vaccinated.HealthSep 25, 2021
![]()
-
Peel Region announces 1st ‘probable’ human case of West Nile virus in 2021"This case reinforces the need for all residents to protect themselves from mosquito bites when outdoors and to remove mosquito breeding sites from their properties."HealthSep 17, 2021
![]()
-
-
Advertisement
-
Attendees of Peel Region hockey tournament urged to seek ‘immediate’ COVID-19 testingTeams from several locations participated in the tournament, including Toronto, Orangeville, Caledon, Georgetown, Woodbridge and Whitby.HealthSep 8, 2021
![]()
-
-
Advertisement
-
Peel Region exploring local options in the absence of COVID-19 vaccine passports in OntarioThe Peel Public Health unit is "actively exploring" with other health units what could be done locally on a vaccine certificate system in the absence of a provincial one.HealthAug 25, 2021
![]()
Trending
-
![]() CRA’s rules for disability tax credit are changing. What to know47,392 Read
CRA’s rules for disability tax credit are changing. What to know47,392 Read -
![]() Jonathan David’s hat trick propels Canada to 1st World Cup win, 6-0 over Qatar23,515 Read
Jonathan David’s hat trick propels Canada to 1st World Cup win, 6-0 over Qatar23,515 Read -
![]() New evidence of origin of the black death a ‘complete surprise’ experts say20,153 Read
New evidence of origin of the black death a ‘complete surprise’ experts say20,153 Read -
![]() ‘Our lives are here’: U.S. man in limbo after Ottawa suspends citizenship12,888 Read
‘Our lives are here’: U.S. man in limbo after Ottawa suspends citizenship12,888 Read -
![]() Trump says he would prefer to see CUSMA ‘terminated’9,899 Read
Trump says he would prefer to see CUSMA ‘terminated’9,899 Read -
![]() Benefit payments are coming soon to those who qualify. Here’s how much8,362 Read
Benefit payments are coming soon to those who qualify. Here’s how much8,362 Read -
Top Videos
-
![]() Global News at 6 Toronto: June 17, 2026
Global News at 6 Toronto: June 17, 2026 -
![]() Toronto mayor welcomes FIFA decision to allow soft water bottles at World Cup matches
Toronto mayor welcomes FIFA decision to allow soft water bottles at World Cup matches -
![]() Olivia Chow finally confirms she’s running for a second term at Toronto’s Mayor
Olivia Chow finally confirms she’s running for a second term at Toronto’s Mayor -
![]() Toronto council pushes to keep FIFA Fan Fest free, but challenges remain
Toronto council pushes to keep FIFA Fan Fest free, but challenges remain -
![]() Toronto fire crews melt Drake ice sculpture
Toronto fire crews melt Drake ice sculpture -
![]() Toronto man who killed 2 strangers 2 days apart found guilty of first-degree murder
Toronto man who killed 2 strangers 2 days apart found guilty of first-degree murder -
![]() Toronto kicks-off spring cleanup campaign
Toronto kicks-off spring cleanup campaign -
![]() Toronto man found guilty of murdering husband in 2021
Toronto man found guilty of murdering husband in 2021 -
![]() U.S. consulate in Toronto hit by gunfire, police declare national security incident
U.S. consulate in Toronto hit by gunfire, police declare national security incident -
![]() Metrolinx sheds 400-plus consultants, some move to become VPs
Metrolinx sheds 400-plus consultants, some move to become VPs -























